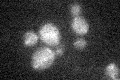
YHR076W

View description
Type 2C protein phosphatase; YHR076W is alternatively spliced to create two mRNA isoforms; protein from spliced form localizes to the mitochondria while the one from the unspliced form is localized to the nuclear envelope
Localization:
Intensity:
Fold change:
Significance:
-
C’ GFP library in SD

cytosol18.75 -
N' NOP1pr-GFP in SD

N/A0 -
N' TEF2pr-mCherry in SD

N/A0 -
N' NATIVEpr-GFP in SD

N/A0 -
N' TEF2pr-VC and Cyto-VN in SD

N/A0 -
C’ GFP library in SD+DTT

cytosol17.360.92No -
C’ GFP library in SD+H2O2
cytosol18.740.99No -
C’ GFP library in Starvation Media

cytosol28.761.53No -
C’ GFP library on the background of Pup2-DaMP

cytosol -
C’ GFP library on the background of CCT mutant

cytosol20.05561.06868No
